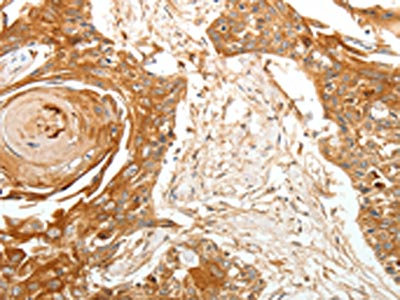

TERT Antibody
-
中文名稱:TERT兔多克隆抗體
-
貨號:CSB-PA257364
-
規格:¥1100
-
圖片:
-
The image on the left is immunohistochemistry of paraffin-embedded Human tonsil tissue using CSB-PA257364(TERT Antibody) at dilution 1/40, on the right is treated with synthetic peptide. (Original magnification: ×200)
-
The image on the left is immunohistochemistry of paraffin-embedded Human esophagus cancer tissue using CSB-PA257364(TERT Antibody) at dilution 1/40, on the right is treated with synthetic peptide. (Original magnification: ×200)
-
-
其他:
產品詳情
-
Uniprot No.:
-
基因名:
-
別名:CMM9 antibody; DKCA2 antibody; DKCB4 antibody; EST2 antibody; HEST2 antibody; htert antibody; hTRT antibody; PFBMFT1 antibody; TCS1 antibody; Telomerase associated protein 2 antibody; Telomerase catalytic subunit antibody; Telomerase reverse transcriptase antibody; Telomerase-associated protein 2 antibody; Telomere Reverse Transcriptase antibody; TERT antibody; TERT_HUMAN antibody; TP2 antibody; TRT antibody
-
宿主:Rabbit
-
反應種屬:Human
-
免疫原:Synthetic peptide of Human TERT
-
免疫原種屬:Homo sapiens (Human)
-
標記方式:Non-conjugated
-
抗體亞型:IgG
-
純化方式:Antigen affinity purification
-
濃度:It differs from different batches. Please contact us to confirm it.
-
保存緩沖液:-20°C, pH7.4 PBS, 0.05% NaN3, 40% Glycerol
-
產品提供形式:Liquid
-
應用范圍:ELISA,IHC
-
推薦稀釋比:
Application Recommended Dilution ELISA 1:3000-1:10000 IHC 1:50-1:200 -
Protocols:
-
儲存條件:Upon receipt, store at -20°C or -80°C. Avoid repeated freeze.
-
貨期:Basically, we can dispatch the products out in 1-3 working days after receiving your orders. Delivery time maybe differs from different purchasing way or location, please kindly consult your local distributors for specific delivery time.
-
用途:For Research Use Only. Not for use in diagnostic or therapeutic procedures.
相關產品
靶點詳情
-
功能:Telomerase is a ribonucleoprotein enzyme essential for the replication of chromosome termini in most eukaryotes. Active in progenitor and cancer cells. Inactive, or very low activity, in normal somatic cells. Catalytic component of the teleromerase holoenzyme complex whose main activity is the elongation of telomeres by acting as a reverse transcriptase that adds simple sequence repeats to chromosome ends by copying a template sequence within the RNA component of the enzyme. Catalyzes the RNA-dependent extension of 3'-chromosomal termini with the 6-nucleotide telomeric repeat unit, 5'-TTAGGG-3'. The catalytic cycle involves primer binding, primer extension and release of product once the template boundary has been reached or nascent product translocation followed by further extension. More active on substrates containing 2 or 3 telomeric repeats. Telomerase activity is regulated by a number of factors including telomerase complex-associated proteins, chaperones and polypeptide modifiers. Modulates Wnt signaling. Plays important roles in aging and antiapoptosis.
-
基因功能參考文獻:
- Results not only identify quadruplex formation in the first exon promoted by CpG dinucleotide methylation as a regulator of hTERT expression but also provide a possible mechanistic insight into the regulation of gene expression via secondary DNA structures. PMID: 29084850
- Findings indicate a critical role for hTERT in regulating the epigenetic clock, in addition to its established role of compensating for cell replication-dependent telomere shortening. PMID: 29374233
- CTC1-STN1 terminates TERT while STN1-TEN1 enables C-strand synthesis during telomere replication in colon cancer cells. PMID: 30026550
- Results show that TERT promoter (TERTp) mutations were detected in 8.5% of papillary thyroid carcinomas (PTCs) with the C228T mutation being the most frequent. Moreover, three novel TERTp alterations were identified, which may play a role in PTC aggressiveness. Also, TERTp hotspot mutations were highly correlated with BRAF V600E mutation and their coexistence was significantly associated with gender and advanced stage. PMID: 30200646
- Presence of TERT promoter mutation is associated with shorter progression free survival and overall survival in meningiomas WHO grade II and III PMID: 29808339
- These data suggest that genetic and epigenetic alterations of TERT are associated with TERT upregulation and may predict clinical outcomes in and young adults melanoma. PMID: 28378855
- We further characterized those epitopes using enzyme-linked immunosorbent assay, and here we discuss the critical epitope of an anti-TERT mAb, which is applicable for immunohistochemical analysis PMID: 30004263
- TERT-p in spitzoid lesions is not necessarily a predictor of poor prognosis PMID: 27930864
- there is an association between TERT promoter mutations and MC1R variants in melanoma patients PMID: 27930874
- The results indicate that the association with chr5p15.33-Region 2 may be explained by rs36115365, a variant influencing TERT expression via ZNF148 in a manner consistent with elevated TERT in carriers of the C allele. PMID: 28447668
- The identified uncommon TERT promoter mutations exacerbate the poor prognosis characteristic of ovarian clear cell carcinoma cases, and the hotspot mutations appear to be a molecular feature of the adenofibroma-associated form of the disease. PMID: 29474637
- hTERT contains a BH3-like motif, a short peptide sequence found in BCL-2 family proteins, and interacts with anti-apoptotic BCL-2 family proteins MCL-1 and BCL-xL PMID: 29937479
- TERT mutation predicted malignant behavior in three cases of follicular thyroid tumors. PMID: 29860621
- the combination of the TERT promoter/BRAFV600E mutations and Ki-67 LI is a promising marker to predict recurrence of PTC. PMID: 28150740
- our study verified the correlations of TGFBR2 and hTERT in vitro and suggests that TGFBR2 and hTERT expression may be used as a diagnostic biomarker for cervical dysplasia and carcinoma. PMID: 28195144
- epigenetic alterations of the TERT promoter are frequent and associated with advanced disease and poorer clinical outcome in adrenocortical carcinoma. PMID: 29956721
- TERT promoter mutations are conserved in the majority of morphologically, spatially and temporally distinct components of a given urothelial carcinoma PMID: 28741734
- hTERT Genetic Polymorphisms and Leukocyte Telomere Length Shortenings are associated with Childhood Acute Lymphoblastic Leukemia. PMID: 29936725
- TERT Promoter Mutation and Telomere Length is associated with Salivary Gland Tumors. PMID: 28664476
- hTERT promoter methylation status revealed non-significant trend towards increase in methylation frequency in head and neck cancer patients compared to healthy individuals. PMID: 30088231
- TERT could induce thyroid carcinoma cell proliferation mainly through the PTEN/AKT signaling pathway. PMID: 29901196
- There was significant prognostic difference among the 4 glioma subtypes. Combined IDH and TERT gene mutation analysis may be useful for prognostic subgrouping. Notably, IDH1 wild-type cases can be further subdivided into TERT(+ ) or (-) subgroups with significant prognostic difference. PMID: 30220117
- EGF significantly upregulated RFPL3 and hTERT protein levels in the nonsmall cell lung cancer cells. RFPL3 and hTERT proteins upregulation by EGF were attenuated by pretreatment with AG1478 and erlotinib. EGF promoted proliferation and inhibited apoptosis; PD98059 decreased RFPL3 and hTERT protein expression; and RFPL3 overexpression increased the expression of hTERT and related MEKpathway proteins PMID: 29749533
- TERT protein expression may be regulated by several mechanisms in addition to its promoter mutation. PMID: 29693015
- Letter: TERT promoter mutation is a genetic cognate of urothelial papilloma, papillary urothelial neoplasm of low malignant potential and urothelial carcinoma, further supporting the hypothesis that TERT mutation is a frequent and early step in the transformation of many urothelial neoplasms. PMID: 28040359
- hTERT promoter mutations associate with aggressive histopathological features, indicating a role in tumour progression in solitary fibrous tumours. PMID: 29703757
- Here it was found that there was no statistical difference between human TERT rs2736109 G>A, rs2735940 T>C, rs2853669 A>G, rs2736098 G>A, and rs2736100 T>G polymorphisms that can be associated with risk of Breast Cancer in a Turkish population. PMID: 29506639
- the TERT promoter mutation may serve as a biomarker of prognostic stratification in patients with papillary urothelial neoplasm of low malignant potential PMID: 29193225
- TERT promoter mutations are very rare in urachal adenocarcinomas (unlike in urothelial carcinoma). PMID: 29047227
- Binary logistic regression analysis showed significant association of TERT rs2736100C with gallbladder carcinoma risk. PMID: 29450669
- We found that THOR is hypermethylated in pancreatic tumor tissue when compared with normal tissue and that THOR methylation correlates with TERT expression in tumor samples. Our preliminary findings support the diagnostic and prognostic values of THOR in pancreatic cancer. PMID: 29019414
- TERT structural rearrangements are associated with metastatic pheochromocytomas. PMID: 28974544
- occurrence of TERT promoter mutations has a pivotal role in the disease progression as a secondary genetic event at a time when tumor cells face the need for telomere elongation to allow further proliferation. PMID: 29463038
- TERT rs2736098: G>A genotype distribution did not differ significantly between patients with DLBCL and controls. PMID: 28967095
- that the rs401681 polymorphism in the TERT-CLPTM1L locus contributes to lung carcinogenesis only in patients harboring an EGFR mutation PMID: 29033187
- Mutated Liquid-based FNAs BRAF, N/HRAS and TERT mutations were significantly associated with malignancy regardless of the cytological classification PMID: 29094776
- TERT promoter mutations were likely to occur in BRAF V600E positive thyroid cancer. Patients with these 2 combined mutations were more likely to have a poor prognosis and outcome. PMID: 30024548
- maternal genetic variations in hTERT may play a contributory role in risk of PTL and PPROM PMID: 29771920
- the mutational status of BRAF, NRAS, and TERT promoter genes in 97 melanomas, was investigated. PMID: 29061376
- PSMA, TERT, and PDEF may serve as a reference for clinical diagnosis and as potential targets for the malignant tumor of the prostate therapeutics PMID: 28829509
- In chronic kidney disease patients, telomerase activity in PBMC was positively correlated with the CKD stage, serum creatinine, potassium and parathormone levels, and negatively correlated with estimated glomerular filtration rate, body mass index, platelet count and serum calcium levels. PMID: 28705647
- experimental evidence for association of higher plasma levels of hTERT with overall survival of both low and high grade patients, presenting hTERT as an independent prognostic marker. PMID: 28756592
- Tumor suppressor functions of MCPH1/BRIT1 and BRCA1; links with the inactivation of the functional form of hTERT and the activation of dominant negative splice variants of hTERT. PMID: 29860064
- results reveal that TERT promoter mutations may contribute significantly to biomarker-based classification of malignant gliomas. PMID: 28868656
- Although Genome-Wide Association studies have not been carried out in the field of alcohol-related hepatocellular carcinoma (HCC), common single nucleotide polymorphisms conferring a small increase in the risk of liver cancer risk have been identified. Specific patterns of gene mutations including CTNNB1, TERT, ARID1A and SMARCA2 exist in alcohol-related HCC. [review] PMID: 28296015
- Mutation frequency in promoter region in non-acral cutaneous metastatic melanoma. PMID: 27301352
- a papillary carcinoma harboring TERT promoter mutation is at higher risk for anaplastic transformation PMID: 28731042
- Meta-analysis: The combination of BRAF and TERT promoter mutations could classify PTCs into four distinct risk groups with decreasing aggressiveness as follows: coexisting BRAF and TERT > TERT alone=BRAF alone > no mutations. PMID: 28666074
- A total of 13 articles and 15 case-control studies, including 9,157 cases and 11,073 controls, were included in this meta-analysis. Overall, the pooled results indicated that the rs2853669 polymorphism was significantly associated with increased cancer risk in a homozygote comparison model. PMID: 29534075
- Authors identified two cancer-specific methylation sites (CpG1 and 2) in the TERT promoter in tumors from GIC patients. Methylated TERT promoter CpG sites 1 and 2 were detectable in patient stool, while only background levels were observed in healthy individuals. PMID: 28754720
顯示更多
收起更多
-
相關疾病:Aplastic anemia (AA); Dyskeratosis congenita, autosomal dominant, 2 (DKCA2); Pulmonary fibrosis, and/or bone marrow failure, telomere-related, 1 (PFBMFT1); Dyskeratosis congenita, autosomal recessive, 4 (DKCB4); Pulmonary fibrosis, idiopathic (IPF); Melanoma, cutaneous malignant 9 (CMM9)
-
亞細胞定位:Nucleus, nucleolus. Nucleus, nucleoplasm. Nucleus. Chromosome, telomere. Cytoplasm. Nucleus, PML body. Note=Shuttling between nuclear and cytoplasm depends on cell cycle, phosphorylation states, transformation and DNA damage. Diffuse localization in the nucleoplasm. Enriched in nucleoli of certain cell types. Translocated to the cytoplasm via nuclear pores in a CRM1/RAN-dependent manner involving oxidative stress-mediated phosphorylation at Tyr-707. Dephosphorylation at this site by SHP2 retains TERT in the nucleus. Translocated to the nucleus by phosphorylation by AKT.
-
蛋白家族:Reverse transcriptase family, Telomerase subfamily
-
組織特異性:Expressed at a high level in thymocyte subpopulations, at an intermediate level in tonsil T-lymphocytes, and at a low to undetectable level in peripheral blood T-lymphocytes.
-
數據庫鏈接:
Most popular with customers
-
-
YWHAB Recombinant Monoclonal Antibody
Applications: ELISA, WB, IHC, IF, FC
Species Reactivity: Human, Mouse, Rat
-
Phospho-YAP1 (S127) Recombinant Monoclonal Antibody
Applications: ELISA, WB, IHC
Species Reactivity: Human
-
-
-
-
-